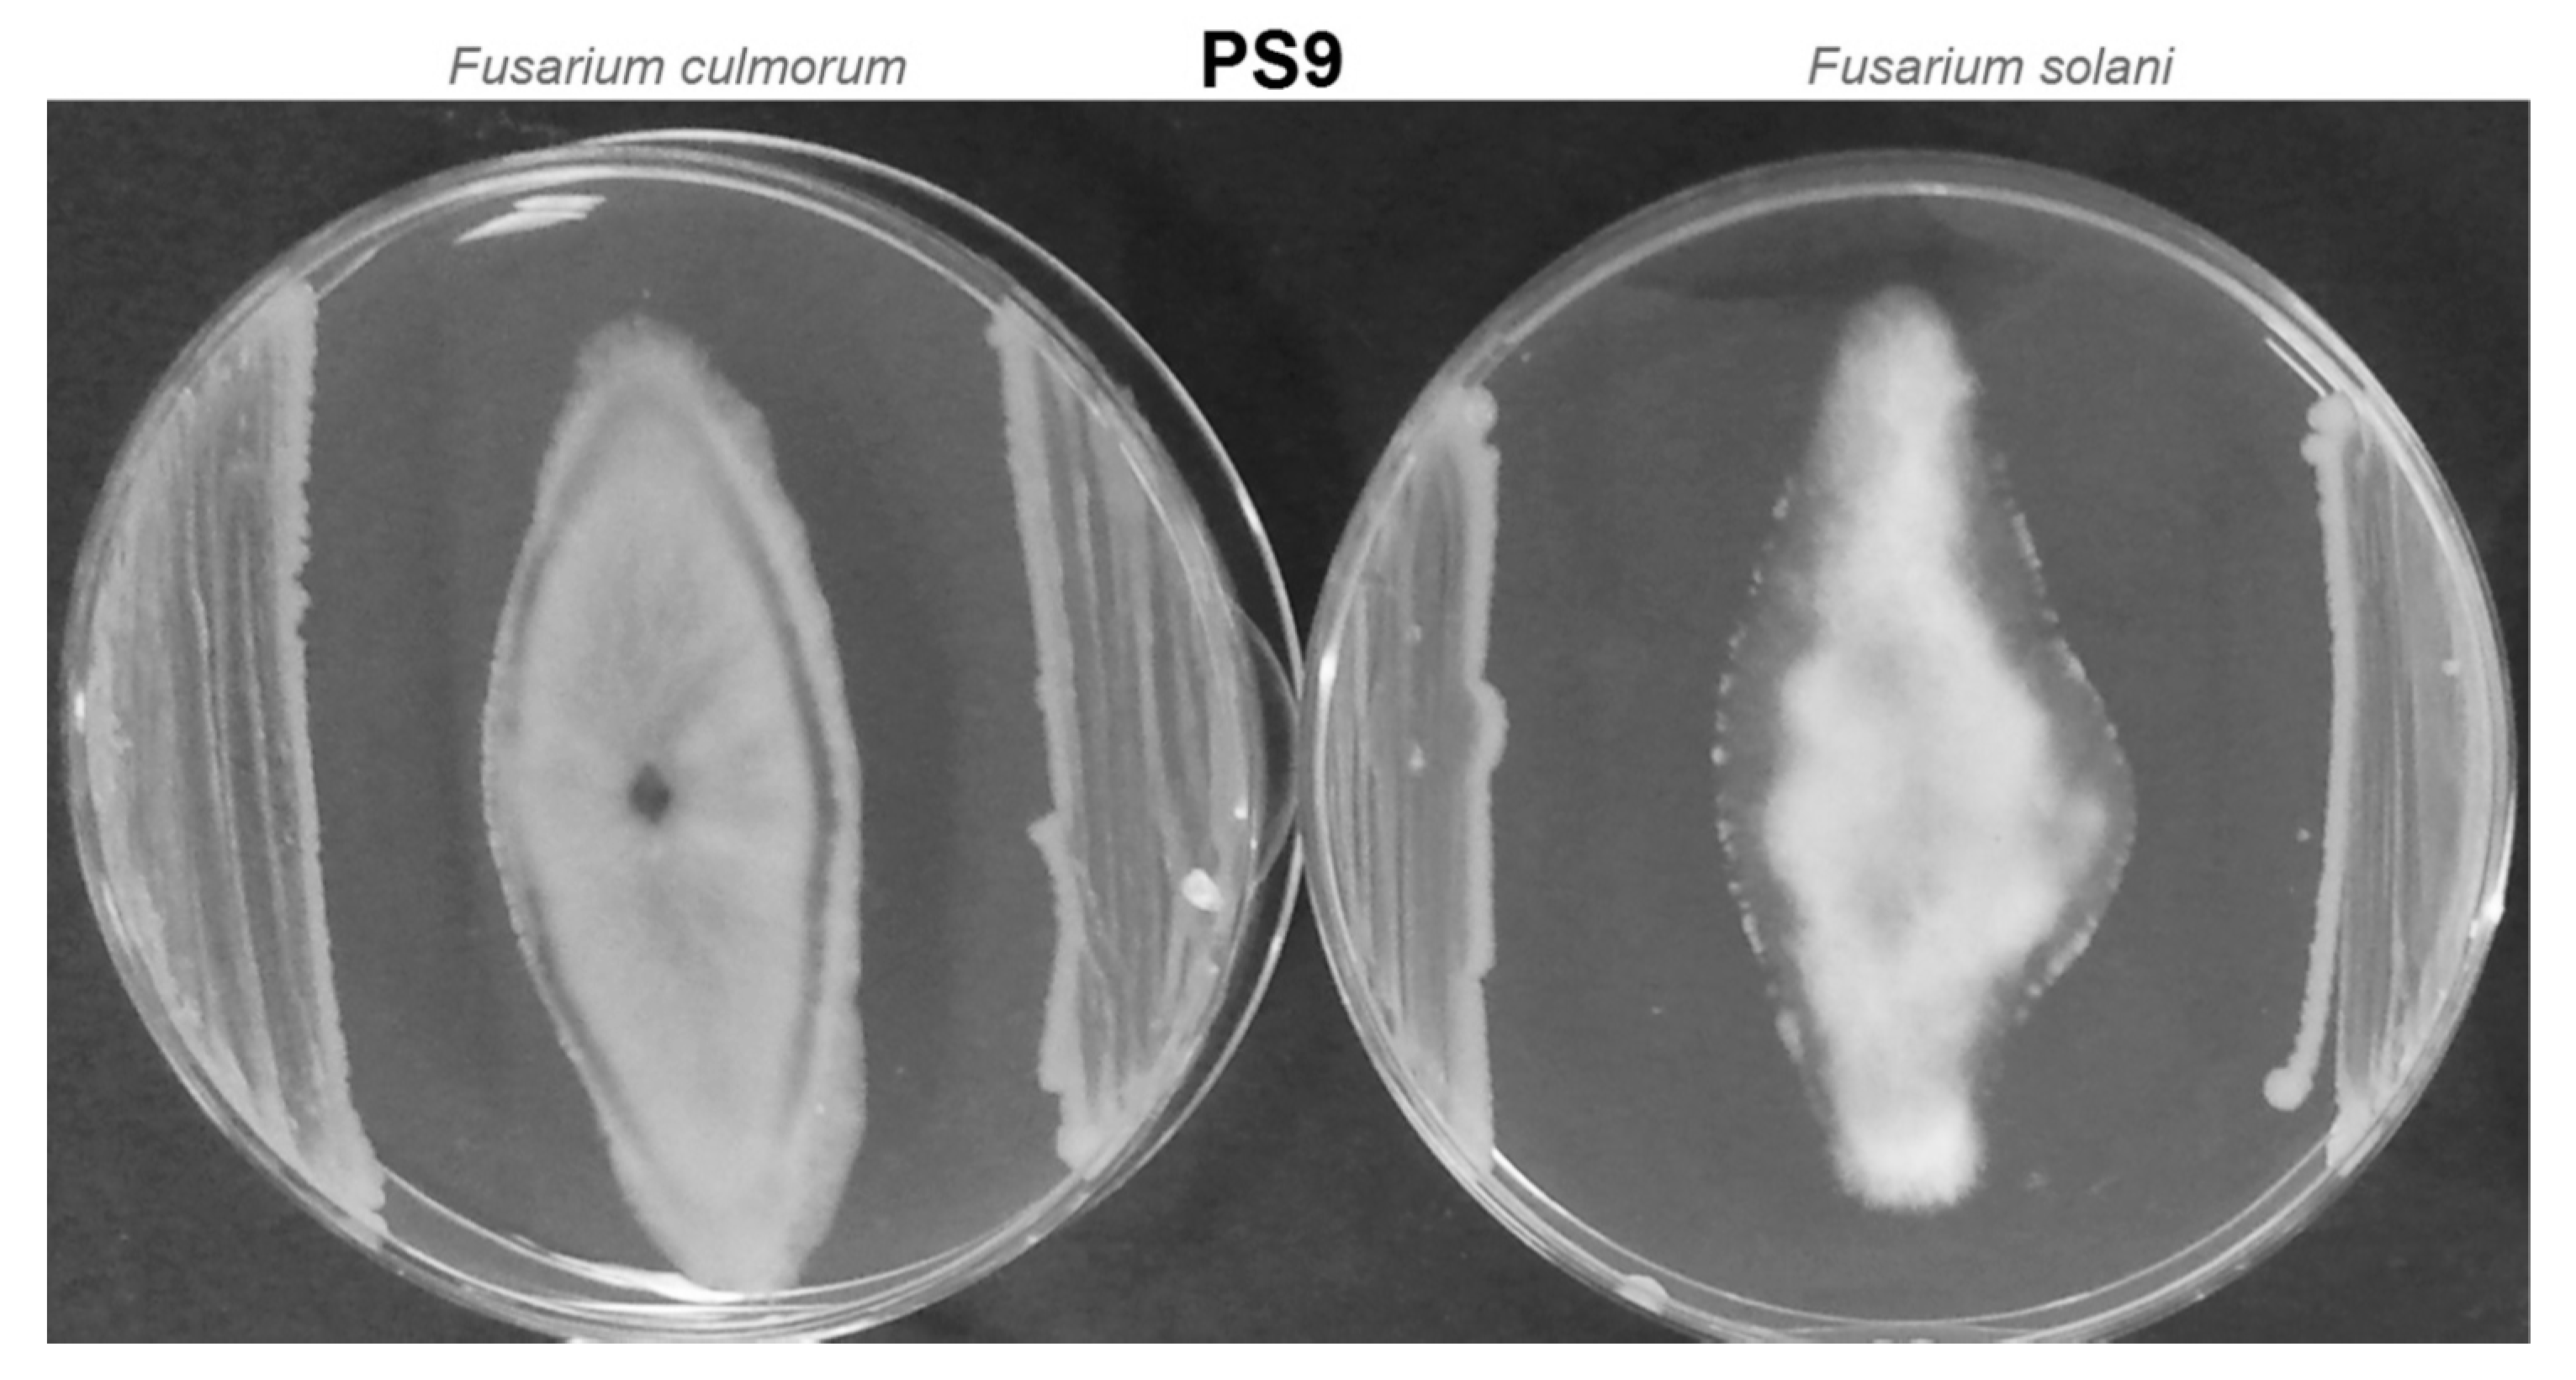
Agronomy 10 01792 g002 Agronomy 10 01792 g002

Bacteria Isolated from the Aeration Chamber of Wastewater Treatment Plants Used in the Biocontrol and Promotion of Wheat Growth
Abstract
1. Introduction
2. Materials and Methods
2.1. Sampling
2.2. Phylogenetic and MALDI-TOF Analysis
2.3. Antagonistic Test
2.4. Enzymatic Activity
2.5. Pot Experiment
- Σ (a·b)—the sum of the products of the degree of scale and the number of plants infected to this degree;
- n—total number of analyzed plants;
- i—the highest degree of scale.
2.6. Statistical Calculations
3. Results
3.1. Identification of Analyzed Strains
3.2. Antagonistic Test
3.3. Enzymatic Activity
3.4. Pot Experiment
4. Discussions
5. Conclusions
Author Contributions
Funding
Acknowledgments
Conflicts of Interest
References
- Beneduzi, A.; Ambrosini, A.; Passaglia, L.M. Plant growth-promoting rhizobacteria (PGPR): Their potential as antagonists and biocontrol agents. Genet. Mol. Biol. 2012, 35, 1044–1051. [Google Scholar] [CrossRef] [PubMed]
- Mendes, R.; Kruijt, M.; de Bruijn, I.; Dekkers, E.; van der Voort, M.; Schneider, J.H.; Piceno, Y.M.; DeSantis, T.Z.; Andersen, G.L.; Bakker, P.A.; et al. Deciphering the rhizosphere microbiome for disease-suppressive bacteria. Science 2011, 332, 1097–1100. [Google Scholar] [CrossRef] [PubMed]
- Ahemad, M.; Kibret, M. Mechanisms and applications of plant growth promoting rhizobacteria: Current perspective. J. King Saud Univ. Sci. 2014, 26, 1–20. [Google Scholar] [CrossRef]
- Bhattacharyya, P.N.; Jha, D.K. Plant growth-promoting rhizobacteria (PGPR): Emergence in agriculture. World J. Microbiol. Biotechnol. 2012, 28, 1327–1350. [Google Scholar] [CrossRef]
- Zaidi, A.; Khan, M.S.; Ahemad, M.; Oves, M. Plant growth promotion by phosphate solubilizing bacteria. Acta Microbiol. Immunol. Hung. 2009, 56, 263–284. [Google Scholar] [CrossRef]
- Hayat, R.; Ali, S.; Amara, U.; Khalid, R.; Ahmed, I. Soil beneficial bacteria and their role in plant growth promotion: A review. Ann. Microbiol. 2010, 60, 579–598. [Google Scholar] [CrossRef]
- Khan, S.; Afzal, M.; Iqbal, S.; Khan, Q.M. Plant-bacteria partnerships for the remediation of hydrocarbon contaminated soils. Chemosphere 2013, 90, 1317–1332. [Google Scholar] [CrossRef]
- Ahemad, M.; Khan, M.S. Evaluation of plant-growth-promoting activities of rhizobacterium Pseudomonas putida under herbicide stress. Ann. Microbiol. 2012, 62, 1531–1540. [Google Scholar] [CrossRef]
- Kang, S.M.; Waqas, M.; Khan, A.L.; Lee, I.J. Plant-Growth-promoting rhizobacteria: Potential candidates for gibberellins production and crop growth promotion. In Use of Microbes for the Alleviation of Soil Stresses, 1st ed.; Miransari, M., Ed.; Springer: New York, NY, USA, 2014; Volume 1, pp. 1–19. [Google Scholar]
- Saharan, B.S.; Nehra, V. Plant growth promoting rhizobacteria: A critical review. Life Sci. Med. Res. 2011, 21, 1–30. [Google Scholar]
- Liu, K.; Newman, M.; McInroy, J.A.; Hu, C.H.; Kloepper, J.W. Selection and assessment of plant growth-promoting rhizobacteria for biological control of multiple plant diseases. Phytopathology 2017, 107, 928–936. [Google Scholar] [CrossRef]
- Orozco-Mosqueda, M.D.C.; Rocha-Granados, M.D.C.; Glick, B.R.; Santoyo, G. Microbiome engineering to improve biocontrol and plant growth-promoting mechanisms. Microbiol. Res. 2018, 208, 25–31. [Google Scholar] [CrossRef] [PubMed]
- Hardoim, P.R.; van Overbeek, L.S.; Berg, G.; Pirttilä, A.M.; Compant, S.; Campisano, A.; Döring, M.; Sessitsch, A. The hidden world within plants: Ecological and evolutionary considerations for defining functioning of microbial endophytes. Microbiol. Mol. Biol. Rev. 2015, 79, 293–320. [Google Scholar] [CrossRef] [PubMed]
- Santoyo, G.; Moreno-Hagelsieb, G.; Orozco-Mosqueda Mdel, C.; Glick, B.R. Plant growth-promoting bacterial endophytes. Microbiol. Res. 2016, 183, 92–99. [Google Scholar] [CrossRef] [PubMed]
- Mhlongo, M.I.; Piater, L.A.; Madala, N.E.; Labuschagne, N.; Dubery, I.A. The chemistry of plant-microbe interactions in the rhizosphere and the potential for metabolomics to reveal signaling related to defense priming and induced systemic resistance. Front. Plant. Sci. 2018, 9, 112. [Google Scholar] [CrossRef] [PubMed]
- Tian, F.; Ding, Y.; Zhu, H.; Yao, L.; Du, B. Genetic diversity of siderophore-producing bacteria of tobacco rhizosphere. Braz. J. Microbiol. 2009, 40, 276–284. [Google Scholar] [CrossRef]
- Waśkiewicz, A.; Stępień, Ł. Mycotoxins biosynthesized by plant-derived Fusarium isolates. Arh. Hig. Rada Toksikol. 2012, 63, 437–445. [Google Scholar] [CrossRef]
- Alonso, V.A.; Pereyra, C.M.; Keller, L.A.; Dalcero, A.M.; Rosa, C.A.; Chiacchiera, S.M.; Cavaglieri, L.R. Fungi and mycotoxins in silage: An overview. J. Appl. Microbiol. 2013, 115, 637–643. [Google Scholar] [CrossRef]
- Przemieniecki, S.W.; Kurowski, T.P.; Korzekwa, K. Chemotypes and geographic distribution of the Fusarium graminearum species complex. Environ. Biotechnol. 2014, 10, 45–59. [Google Scholar] [CrossRef]
- Przemieniecki, S.W.; Damszel, M.; Kurowski, T.P.; Mastalerz, J.; Kotlarz, K. Identification, ecological evaluation and phylogenetic analysis of non-symbiotic endophytic fungi colonizing timothy grass and perennial ryegrass grown in adjacent plots. Grass Forage Sci. 2019, 74, 42–52. [Google Scholar] [CrossRef]
- Mojid, M.A.; Hossain, A.B.M.Z.; Wyseure, G.C.L. Impacts of municipal wastewater on basic soil properties as evaluated by soil column leaching experiment in laboratory. J. Soil Sci. Plant Nutr. 2019, 19, 402–412. [Google Scholar] [CrossRef]
- Eid, E.M.; Hussain, A.A.; Taher, M.A.; Galal, T.M.; Shaltout, K.H.; Sewelam, N. Sewage sludge application enhances the growth of Corchorus olitorius plants and provides a sustainable practice for nutrient recirculation in agricultural soils. J. Soil Sci. Plant Nutr. 2020, 20, 149–159. [Google Scholar] [CrossRef]
- Khalilzadeh, R.; Pirzad, A.; Sepehr, E.; Anwar, S. Long-Term effect of heavy metal–polluted wastewater irrigation on physiological and ecological parameters of Salicornia europaea L. J. Soil Sci. Plant Nutr. 2020, 20, 1574–1587. [Google Scholar] [CrossRef]
- Liu, W.; Zhao, J.; Ouyang, Z.; So, L. Impacts of sewage irrigation on heavy metal distribution and contamination in Beijing, China. Environ. Int. 2005, 31, 805–812. [Google Scholar] [CrossRef] [PubMed]
- Hajihashemi, S.; Mbarki, S.; Skalicky, M.; Noedoost, F.; Raeisi, M.; Brestic, M. Effect of wastewater irrigation on photosynthesis, growth, and anatomical features of two wheat cultivars (Triticum aestivum L.). Water 2020, 12, 607. [Google Scholar] [CrossRef]
- Rodríguez-Morgado, B.; Gómez, I.; Parrado, J.; García-Martínez, A.M.; Aragón, C.; Tejada, M. Obtaining edaphic biostimulants/biofertilizers from different sewage sludges. Effects on soil biological properties. Environ. Technol. 2015, 36, 2217–2226. [Google Scholar] [CrossRef] [PubMed]
- Olanrewaju, O.S.; Glick, B.R.; Babalola, O.O. Mechanisms of action of plant growth promoting bacteria. World J. Microbiol. Biotechnol. 2017, 33, 197. [Google Scholar] [CrossRef]
- Jastrzębska, M.; Kostrzewska, M.K. Using an environment-friendly fertilizer from sewage sludge ash with the addition of bacillus megaterium. Minerals. 2019, 9, 423. [Google Scholar] [CrossRef]
- Xu, L.; Geelen, D. Developing biostimulants from agro-food and industrial by-products. Front. Plant Sci. 2018, 9, 1567. [Google Scholar] [CrossRef]
- Rodríguez-Morgado, B.; Caballero, P.; Paneque, P.; Gómez, I.; Parrado, J.; Tejada, M. Obtaining edaphic biostimulants/biofertilizers from sewage sludge using fermentative processes. Short-time effects on soil biochemical properties. Environ. Technol. 2019, 40, 399–406. [Google Scholar] [CrossRef]
- Shchegolkova, N.M.; Krasnov, G.S.; Belova, A.A.; Dmitriev, A.A.; Kharitonov, S.L.; Klimina, K.M.; Melnikova, N.V.; Kudryavtseva, A.V. Microbial community structure of activated sludge in treatment plants with different wastewater compositions. Front. Microbiol. 2016, 7, 90. [Google Scholar] [CrossRef]
- Lane, D.J. 16S/23S rRNA sequencing. In Nucleic Acid Techniques in Bacterial Systematics, 1st ed.; Stackebrandt, E., Goodfellow, M., Eds.; John Wiley & Sons, Inc.: New York, NY, USA, 1991; pp. 115–175. [Google Scholar]
- Przemieniecki, S.W.; Kurowski, T.P.; Damszel, M.; Krawczyk, K.; Karwowska, A. Effectiveness of the Bacillus sp. SP-A9 strain as a biological control agent for spring wheat (Triticum aestivum L.). J. Agric. Sci. Tech. 2018, 20, 609–619. [Google Scholar]
- Liu, X.; Liu, C. Effects of drought-stress on fusarium crown rot development in barley. PLoS ONE 2016, 11, e0167304. [Google Scholar] [CrossRef] [PubMed]
- Przemieniecki, S.W.; Kurowski, T.P.; Kotlarz, K.; Krawczyk, K.; Damszel, M.; Karwowska, A. Plant growth promoting properties of Serratia fonticola ART 8 and Pseudomonas putida ART 9 and their effect on the growth of spring wheat (Triticum aestivum L.). Environ. Biotechnol. 2016, 12, 35–39. [Google Scholar] [CrossRef]
- Mahmood, A.; Turgay, O.C.; Farooq, M.; Hayat, R. Seed biopriming with plant growth promoting rhizobacteria: A review. FEMS Microbiol. Ecol. 2016, 92, 112. [Google Scholar] [CrossRef]
- Ahemad, M.; Khan, M.S. Effect of fungicides on plant growth promoting activities of phosphate solubilizing Pseudomonas putida isolated from mustard (Brassica compestris) rhizosphere. Chemosphere 2012, 86, 945–950. [Google Scholar] [CrossRef] [PubMed]
- Przemieniecki, S.W.; Kurowski, T.P.; Kotlarz, K.; Krawczyk, K.; Damszel, M.; Pszczółkowska, A.; Kacprzak-Siuda, K.; Chareńska, A.; Mastalerz, J. Bacteria isolated from treated wastewater for biofertilization and crop protection against fusarium spp. pathogens. J. Soil Sci. Plant Nutr. 2019, 19, 1–11. [Google Scholar] [CrossRef]
- Przemieniecki, S.W.; Kurowski, T.P.; Karwowska, A. Plant growth promoting potential of Pseudomonas sp. SP0113 isolated from potable water a closed water well. Arch. Biol. Sci. 2015, 67, 663–673. [Google Scholar] [CrossRef]
- Hudec, K.; Muchová, D. Influence of temperature and species origin on Fusarium spp. and Microdochium nivale pathogenicity to wheat seedlings. Plant Protect. Sci. 2010, 46, 59–65. [Google Scholar] [CrossRef]
- Abuamsha, R.; Salman, M.; Ehlers, R. Effect of seed priming with Serratia plymuthica and Pseudomonas chlororaphis to control Leptosphaeria maculans in different oilseed rape cultivars. Eur. J. Plant Pathol. 2011, 130, 287–295. [Google Scholar] [CrossRef]
- Goswami, D.; Vaghela, H.; Parmar, S.; Dhandhukia, P.; Thakker, J. Plant growth promoting potentials of Pseudomonas spp. Strain OG isolated from marine water. J. Plant Interact. 2013, 8, 281–290. [Google Scholar] [CrossRef]
- Cummings, S.P. The application of plant growth promoting rhizobacteria (PGPR) in low input and organic cultivation of graminaceous crops; potential and problems. Environ. Biotechnol. 2009, 5, 43–50. [Google Scholar]
- Witte, C.P. Urea metabolism in plants. Plant Sci. 2011, 180, 431–438. [Google Scholar] [CrossRef] [PubMed]
- Przemieniecki, S.W.; Kurowski, T.P.; Damszel, M.; Karwowska, A.; Adamiak, E. Effect of Roundup 360 SL on survival of Pseudomonas sp. SP0113 strain and effective control of phytopathogens. J. Agric. Sci. Tech. 2017, 19, 1417–1427. [Google Scholar]
- Przemieniecki, S.W.; Kurowski, T.P.; Kotlarz, K.; Mastalerz, J. The ability of Pseudomonas sp. SP0113 to solubilize tricalcium phosphate and its influence on the development of spring wheat. Pol. J. Environ. Stud. 2019, 28, 3533–3538. [Google Scholar] [CrossRef]
- Ben Rebah, F.; Prévost, D.; Yezza, A.; Tyagi, R.D. Agro-industrial waste materials and wastewater sludge for rhizobial inoculant production: A review. Bioresour. Technol. 2007, 98, 3535–3546. [Google Scholar] [CrossRef]

| Pathogen | F. culmorum | F. solani | ||||
|---|---|---|---|---|---|---|
| PGPB Strain | Ps-1 | Ps-9 | Ps-15 | Ps-1 | Ps-9 | Ps-15 |
| % inhibition | 50.23 cd * | 68.37 A | 63.00 ab | 43.53 d | 66.47 A | 56.73 bc |
| Biochemical Properties | Strain | |||
|---|---|---|---|---|
| Ps-1 | Ps-9 | Ps-15 | ||
| Enzymatic activity | Alkaline phosphatase | + | + | + |
| Acid phosphatase | + | + | + | |
| Esterase (C 4) | + | + | + | |
| Ester lipase (C 8) | + | + | + | |
| Lipase (C 14) | ± | ± | + | |
| Leucine arylamidase | + | + | + | |
| Valine arylamidase | + | + | + | |
| Cystine arylamidase | ± | ± | ± | |
| Trypsin | + | + | + | |
| α-Chymotrypsin | − | − | - | |
| Naphthol-AS-BI phosphohydrolase | + | + | + | |
| α-Galactosidase | − | − | − | |
| β- Galactosidase | + | + | + | |
| β-Glucoronidase | − | − | − | |
| α-Glucosidase | + | + | + | |
| β- Glucosidase | ± | ± | ± | |
| N-Acetyl-β-glucosaminidase | + | + | + | |
| α-Mannosidase | − | − | − | |
| α-Fructosidase | − | − | − | |
| Arginine dihydrolase | − | − | − | |
| Urease | − | − | − | |
| Protease | + | + | + | |
| Assimilation | D-Glucose | ± | + | + |
| L-Arabinose | ± | − | − | |
| D-Mannose | + | + | + | |
| D-Mannitol | + | + | + | |
| N-Acetylglucosamine | + | + | + | |
| D-Maltose | + | + | + | |
| Potassium gluconate | + | + | + | |
| Capric acid | + | + | + | |
| Adipic acid | − | − | − | |
| Malic acid | + | + | + | |
| Trisodium citrate | ± | + | + | |
| Phenylacetic acid | − | − | − | |
| Reduction of nitrate to nitrite | + | + | + | |
| Reduction of nitrate to nitrogen | − | − | − | |
| Indole production | − | − | − | |
| D-Glucose fermentation | + | + | + | |
| P-solubilization | − | + | − | |
| Ammonification | ± | + | + | |
| Parameter | Control | F. culmorum | F. solani | ||||||
|---|---|---|---|---|---|---|---|---|---|
| None | Ps-1 | Ps-9 | Ps-15 | none | Ps-1 | Ps-9 | Ps-15 | ||
| Grain weight per ear [g] | 2.65 cd | 2.44 e | 2.51 de | 3.27 a | 2.68 cd | 2.35 e | 2.72 c | 3 b | 2.67 cd |
| Ear length [cm] | 4.32 b | 4.17 b | 4.51 ab | 4.89 a | 4.64 a | 4.22 c | 5.69 a | 5.05 b | 4.54 b-d |
| Ear weight [g] | 3.50 b | 2.84 c | 3.84 ab | 4.10 a | 3.39 b | 2.96 c | 3.71 ab | 3.33 b | 3.75 ab |
| Ear dry mass [%] | 88.43 ab | 89.25 ab | 90.11 a | 88.86 ab | 89.32 ab | 87.69 b | 89.42 ab | 89.94 a | 89.59 ab |
| Stalk length [cm] | 49.04 a | 47.25 a | 42.76 b | 46.59 a | 49.25 a | 45.97 b | 45.52 b | 45.82 b | 45.38 b |
| Root length [cm] | 7.76 cd | 6.98 c | 8.34 bc | 9.2 a | 7.68 cd | 7.26 d | 11.7 ab | 12.38 A | 13.2 A |
| Root weight [g] | 1.60 a | 1.56 ab | 1.92 a | 1.76 a | 1.64 a | 1.39 b | 2.22 a | 1.88 a | 2.11 a |
| Root dry mass [%] | 34.33 b | 41.57 ab | 43.83 a | 43.79 a | 44.80 a | 44.52 a | 44.37 a | 44.31 a | 45.40 a |
| Disease Index (DI) [%] | 24.1 ef | 68.5 b | 51.9 cd | 5.6 g | 33.3 ef | 92.6 A | 55.6 bc | 5.6 g | 37.0 de |
Publisher’s Note: MDPI stays neutral with regard to jurisdictional claims in published maps and institutional affiliations. |
© 2020 by the authors. Licensee MDPI, Basel, Switzerland. This article is an open access article distributed under the terms and conditions of the Creative Commons Attribution (CC BY) license (http://creativecommons.org/licenses/by/4.0/).
Share and Cite
Przemieniecki, S.W.; Gorczyca, A.; Matras, E.; Krawczyk, K.; Mastalerz, J.; Zakrzewski, A. Bacteria Isolated from the Aeration Chamber of Wastewater Treatment Plants Used in the Biocontrol and Promotion of Wheat Growth. Agronomy 2020, 10, 1792. https://doi.org/10.3390/agronomy10111792
Przemieniecki SW, Gorczyca A, Matras E, Krawczyk K, Mastalerz J, Zakrzewski A. Bacteria Isolated from the Aeration Chamber of Wastewater Treatment Plants Used in the Biocontrol and Promotion of Wheat Growth. Agronomy. 2020; 10(11):1792. https://doi.org/10.3390/agronomy10111792
Chicago/Turabian StylePrzemieniecki, Sebastian Wojciech, Anna Gorczyca, Ewelina Matras, Krzysztof Krawczyk, Jędrzej Mastalerz, and Arkadiusz Zakrzewski. 2020. "Bacteria Isolated from the Aeration Chamber of Wastewater Treatment Plants Used in the Biocontrol and Promotion of Wheat Growth" Agronomy 10, no. 11: 1792. https://doi.org/10.3390/agronomy10111792
APA StylePrzemieniecki, S. W., Gorczyca, A., Matras, E., Krawczyk, K., Mastalerz, J., & Zakrzewski, A. (2020). Bacteria Isolated from the Aeration Chamber of Wastewater Treatment Plants Used in the Biocontrol and Promotion of Wheat Growth. Agronomy, 10(11), 1792. https://doi.org/10.3390/agronomy10111792

